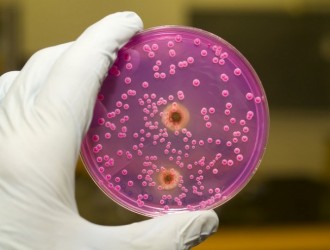

Данная программа восстановления и сохранения здоровья разработана Академией Здоровья Coral Club . По материалам книги О.А. Бутаковой «Сборник оздоровительных ...
Данная программа восстановления и сохранения здоровья разработана Академией Здоровья Coral Club . По материалам книги О.А. Бутаковой «Сборник оздоровительных программ».Нутрициологические ...
Диабет бывает двух типов, но общий признак заболевания – повышенная концентрация сахара (глюкозы) в крови. Больные диабетом люди озабочены уровнем сахара в крови, а потому ищут различные ...
Витамин B9 (фолиевая кислота) обладает удивительными полезными свойствами, некоторые ученые называют его «витамин хорошего настроения». Именно фолиевая кислота необходима для выработки гормонов «счастья» и обеспечивает хорошее ...
Печень – один из наиболее важных и значимых органов, находящийся в непрерывной работе, как и наше сердце, взаимодействующий со всей пищеварительной системой . Печень трудится без отдыха ...
Программа при бактериальных, вирусных и грибковых инфекциях Данная программа восстановления и сохранения ...
Данная программа восстановления и сохранения здоровья разработана Академией Здоровья Coral Club . По материалам книги ...